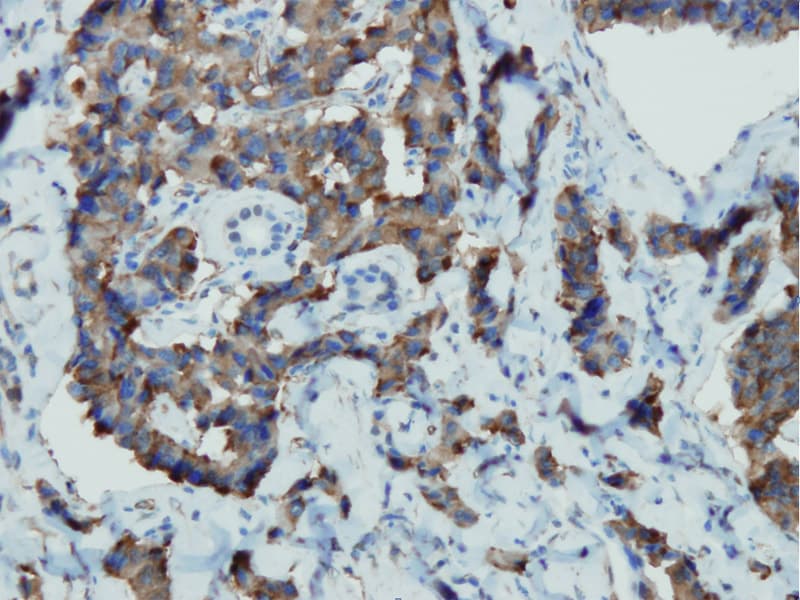

Anti-Cromogranina A CE/IVD para IHC - Patologia da cabeça e pescoço
A cromogranina A (CgA) é uma proteína de 86 kDa que é o principal membro da família de granina das glicoproteínas secretoras ácidas localizadas em grânulos neurosecretos de células neuroendócrinas. A cromogranina A mostrou ampla expressão nos tecidos endócrinos, incluindo a hipófise, medula adrenal, tiróide, ilhotas pancreáticas e tracto gastrointestinal. A cromogranina A representa o marcador mais específico de diferenciação neuroendócrina em uso geral. É útil para a identificação de tumores neuroendócrinos.
É um excelente marcador para tumores de carcinoides, feocromocitomas, paragangliomas, e outros tumores neuroendócrinos. A coexpressão da cromogranina A e da enolase específica dos neurónios (NSE) é comum em neoplasias neuroendócrinas. Alegadamente, a co-expressão de certas queratinas e da cromogranina indica a linhagem neuroendócrina. A presença de forte coloração anti-cromogranina e a ausência de coloração anti-queratina deve aumentar a possibilidade de paraganglioma. A co-expressão da cromogranina e da NSE é típica das neoplasias neuroendócrinas. A maioria dos adenomas pituitários e prolactinomas exprimem facilmente a cromogranina.

Pancreas
Pancreas
Resultado da sua pesquisa : 8 produto encontrado
Refine sua procura :
RUO
CE/IVD
NEW
- Unconjugated 8
- human 5
- monkey 2
- mouse 2
- pig 2
- rat 2
- mouse 8
- Primary antibody
- IHC 8
- LK2H10 & PHE5 5
- A3 3
Referência
Descrição
Cond.
Price Bef. VAT
‹
›


